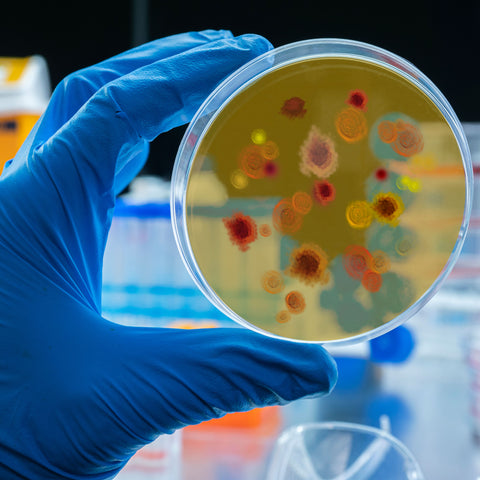

Collection list

Review us on Google
Please write a review for Selectech Laboratory Equipment Supplier on Google Reviews and add your rating of your experience.
Thanks to all our clients for getting us where we are today!
SELECTECH
Warich Close Office Park
39 Van Vuuren Street
Building 3, Ground Floor
Honeydew Ridge
Johannesburg
2000
(Opposite Clearwater Mall)